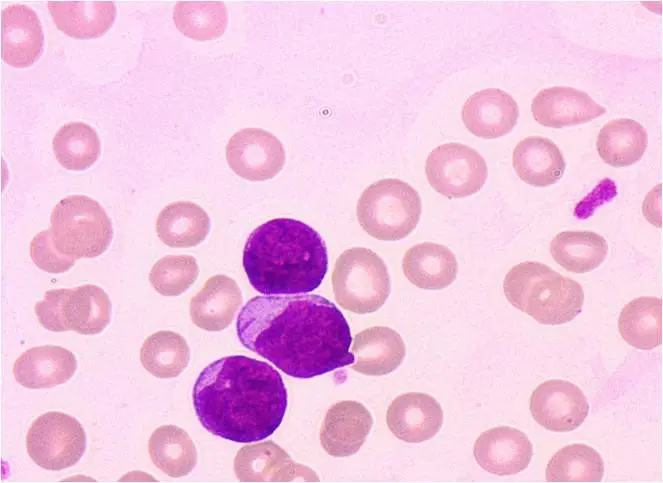
圖片

110年:(醫檢)血液(1)
小美最近兩個星期覺得異常疲累,臉色發白,發燒,喉嚨痛,頸部淋巴腫,下肢瘀青。就診抽血發現,血色素8.5 g/dL,白血球 56,340/μL ,血小板 12,000/μL ,周邊血液抹片如下圖,最可能的診斷為下列何者?
A急性咽喉炎併發 leukemoid reaction
B急性淋巴性白血病( acute lymphoblastic leukemia )
C急性骨髓性白血病( acute myeloid leukemia )
D急性病毒感染併發吞噬血球症候群( hemophagocytic syndrome )
詳細解析
本題觀念:
本題考查**急性白血病(Acute Leukemia)**的臨床表現與血液抹片形態學鑑別診斷。解題關鍵在於辨識「白血病裂孔(Leukemic hiatus)」現象(即周邊血出現大量芽細胞)以及最具特異性的形態特徵——奧爾氏棒(Auer rod)。
影像分析:
- 細胞特徵:圖中可見數個大型的單核細胞,這些細胞具有高核質比(High N/C ratio),細胞核大且染色質呈現細緻、疏鬆的未成熟樣貌(Blastic chromatin),部分可見核仁(Nucleoli)。這些特徵顯示它們是芽細胞(Blasts)。
- 關鍵發現(Key Finding):請仔細觀察位於畫面中央、稍微偏下方的那個芽細胞。在其灰藍色的細胞質中,有一條明顯的、呈紫紅色的針狀/棒狀結構。這就是奧爾氏棒(Auer rod)。
- 形態學診斷:Auer rod 是由融合的初級顆粒(Primary granules/Lysosomes)組成,僅存在於骨髓系(Myeloid lineage)的細胞中。一旦在芽細胞中發現 Auer rod,即可形態學上排除淋巴球性白血病(ALL),確診為急性骨髓性白血病(AML)。
選項分析:
- **A. 急性咽喉炎併發 leukemoid reaction
...(解析預覽)...

升級 VIP 解鎖圖文解析